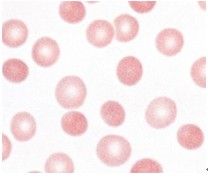
紅細胞檢查
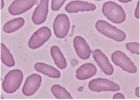
橢圓形紅細胞：增多見於遺傳橢（遺傳性橢圓形紅細胞增多症）。
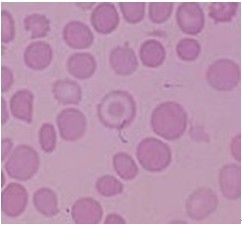
靶形紅細胞：增多見於地中海貧血。
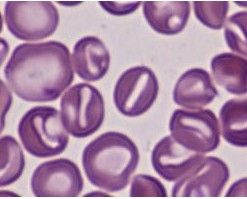
口形紅細胞：增多見於遺傳口（遺傳性口形紅細胞增多症）。
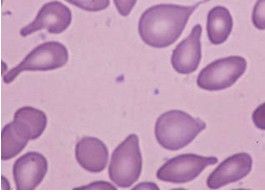
淚滴形紅細胞
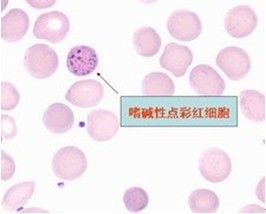
嗜鹼性點彩紅細胞：增多見於鉛中毒等。

概要
正常紅細胞
正常紅細胞紅細胞生理
平均壽命120天。
血紅蛋白正常值
成年男性:120~160g/L
成年女性:110~150g/L
新生兒:170~200g/L
兒童:110~160g/L
計數
檢測原理
紅細胞稀釋液為Hayem液。氯化鈉作用是調節滲透壓,硫酸鈉提高比密防止細胞粘連,氯化高汞是防腐劑。
方法學評價
高球蛋白血症患者由於球蛋白沉澱使紅細胞容易凝集。
臨床意義
生理變化:①精神因素(刺激後RBC升高)、體力勞動(RBC升高)、大氣壓(高原地區RBC濃度升高)、妊娠(降低)可影響紅細胞濃度。
病理變化:①增多:Ⅰ相對增多:血漿中水分丟失(嘔吐、腹瀉、多汗、多尿、大面積燒傷);Ⅱ絕對性增多:慢性肺心病;Ⅲ真性RBC增多症。
血紅蛋白測定
橢圓形紅細胞:增多見於遺傳橢(遺傳性橢圓形紅細胞增多症)
橢圓形紅細胞:增多見於遺傳橢(遺傳性橢圓形紅細胞增多症)檢測原理:參考方法為氰化高鐵血紅蛋白測定法,測定波長540nm。
方法學評價:氰化高鐵血紅蛋白(HiCN)測定法試劑劇毒,高白細胞和高球蛋白血症可致結果假性升高。十二烷基硫酸鈉血紅蛋白(SDS-Hb)測定法試劑無公害,被推薦為次選方法。
形態檢查
靶形紅細胞:增多見於地中海貧血。
靶形紅細胞:增多見於地中海貧血。1.大小異型
小紅細胞:直徑<6um。增多見於缺鐵性貧血(IDA)、地中海貧血(珠蛋白生成障礙性貧血)、遺傳球(遺傳性球形紅細胞增多症)。
大紅細胞:直徑>10um。見於巨幼貧(維生素B12或葉酸缺乏)。
巨紅細胞:直徑>15um。見於巨幼貧。
紅細胞大小不均:見於嚴重的增生性貧血,如巨幼貧等。
2 .紅細胞形態改變
球形紅細胞(MCHC升高;典型的巨幼貧的MCV、MCH升高,但MCHC正常。):無中心淡染區,增多見於遺傳球。
橢圓形紅細胞:增多見於遺傳橢(遺傳性橢圓形紅細胞增多症)。
 鐮形紅細胞:增多見於HbS病(鐮狀細胞性貧血)。
鐮形紅細胞:增多見於HbS病(鐮狀細胞性貧血)。靶形紅細胞:增多見於地中海貧血。
口形紅細胞:增多見於遺傳口(遺傳性口形紅細胞增多症)。
棘細胞:紅細胞表面有針尖狀突起,其間距不規則,突起的長度和寬度可不一。增多見於β-脂蛋白缺乏症(LDL)。
皺縮紅細胞:周邊呈鋸齒狀排列緊密,大小不等,外端較尖。增多見於細胞脫水。
淚滴形紅細胞:
紅細胞形態不整(RDW升高):最常見於巨幼貧。
3 .紅細胞內血紅蛋白含量改變
D正常色素性:AA、白血病。
低色素性(MCH、MCHC降低):IDA、地中海貧血。
口形紅細胞:增多見於遺傳口(遺傳性口形紅細胞增多症)。
口形紅細胞:增多見於遺傳口(遺傳性口形紅細胞增多症)。高色素性:巨幼貧。
4 紅細胞中出現異常結構
豪喬小體(H-J小體):為核殘餘物,增多見於巨幼貧。
卡波環:細胞質中脂蛋白變形所致,增多見於巨幼貧。
嗜鹼性點彩紅細胞:增多見於鉛中毒等。
有核紅細胞:正常成人外周血中不可見,1周內嬰兒外周血中可見少量。增多見於溶貧、急慢性白血病。
比容測定
 棘細胞:紅細胞表面有針尖狀突起,其間距不規則,突起的長度和寬度可不一。增多見於β-脂蛋白(LDL)缺乏症。
棘細胞:紅細胞表面有針尖狀突起,其間距不規則,突起的長度和寬度可不一。增多見於β-脂蛋白(LDL)缺乏症。方法學評價
參考法為放射性核素法
血細胞分析儀測量原理Hct=MCV×RBC
離心法缺點:無法完全排除RBC之間的殘留血漿
臨床意義
Hct升高見於RBC升高,此外,測定Hct可了解血液濃縮程度,作為補液計算的依據。
Hct降低見於各種類型的貧血。
平均指數
 皺縮紅細胞:周邊呈鋸齒狀排列緊密,大小不等,外端較尖。增多見於細胞脫水。
皺縮紅細胞:周邊呈鋸齒狀排列緊密,大小不等,外端較尖。增多見於細胞脫水。缺鐵貧、地中海貧血:小細胞低色素性貧血,MCV、MCH、MCHC都下降。
再障:正細胞性貧血,MCV、MCH、MCHC都正常。
巨幼貧血:大細胞高色素性貧血,MCV升高、MCH升高、MCHC正常。
分布寬度
反映細胞體積大小是否均一,體積變化越大,RDW越大。
缺鐵貧時RDW升高;巨幼貧RDW升高。
網織紅細胞計數
淚滴形紅細胞
淚滴形紅細胞檢測原理
染色物質:細胞質中嗜鹼性物質RNA。
染色方法:煌焦油藍或新亞甲藍等活體染色法。
方法學評價
使用米勒窺盤計數,方法簡單,減少了實驗誤差。
臨床意義
判斷骨髓紅系統造血情況,急性失血後5-10天,RET達高峰。
作為貧血療效觀察指標。
點彩紅細胞計數
 豪喬小體(H-J小體):為核殘餘物,增多見於巨幼貧。
豪喬小體(H-J小體):為核殘餘物,增多見於巨幼貧。檢測原理
染色物質:重金屬中毒時,細胞質中嗜鹼性物質RNA變性沉澱而形成。
染色方法:瑞氏染色。
沉降率測定
嗜鹼性點彩紅細胞:增多見於鉛中毒等。
嗜鹼性點彩紅細胞:增多見於鉛中毒等。影響ESR因素
ESR升高 ESR降低
血漿因素 纖維蛋白原、球蛋白、膽固醇升高 白蛋白、糖蛋白、卵磷脂升高
RBC因素 嚴重貧血;RBC直徑越大,厚度越薄,ESR越快 RBC增多症;球形RBC,ESR緩慢。
臨床意義
生理性
婦女月經期,60歲以上的老年人。
病理性
各種炎症:臨床上常用來觀察結核病、風濕熱有無活動性。
組織損傷及壞死:心絞痛時正常,心肌梗塞時增快。
惡性腫瘤:良性腫瘤時正常,惡性腫瘤時加快。
各種原因導致的高球蛋白血症:多發性骨髓瘤(IgA、IgG、IgE、IgD)、巨球蛋白血症(IgM),但是某些巨球蛋白血症患者IgM明顯增多而使血漿粘稠度增高即高粘綜合症時,反而抑制ESR,使ESR減慢。
觀察急性炎症時用WBC多見;觀察慢性炎症時用ESR多見。
